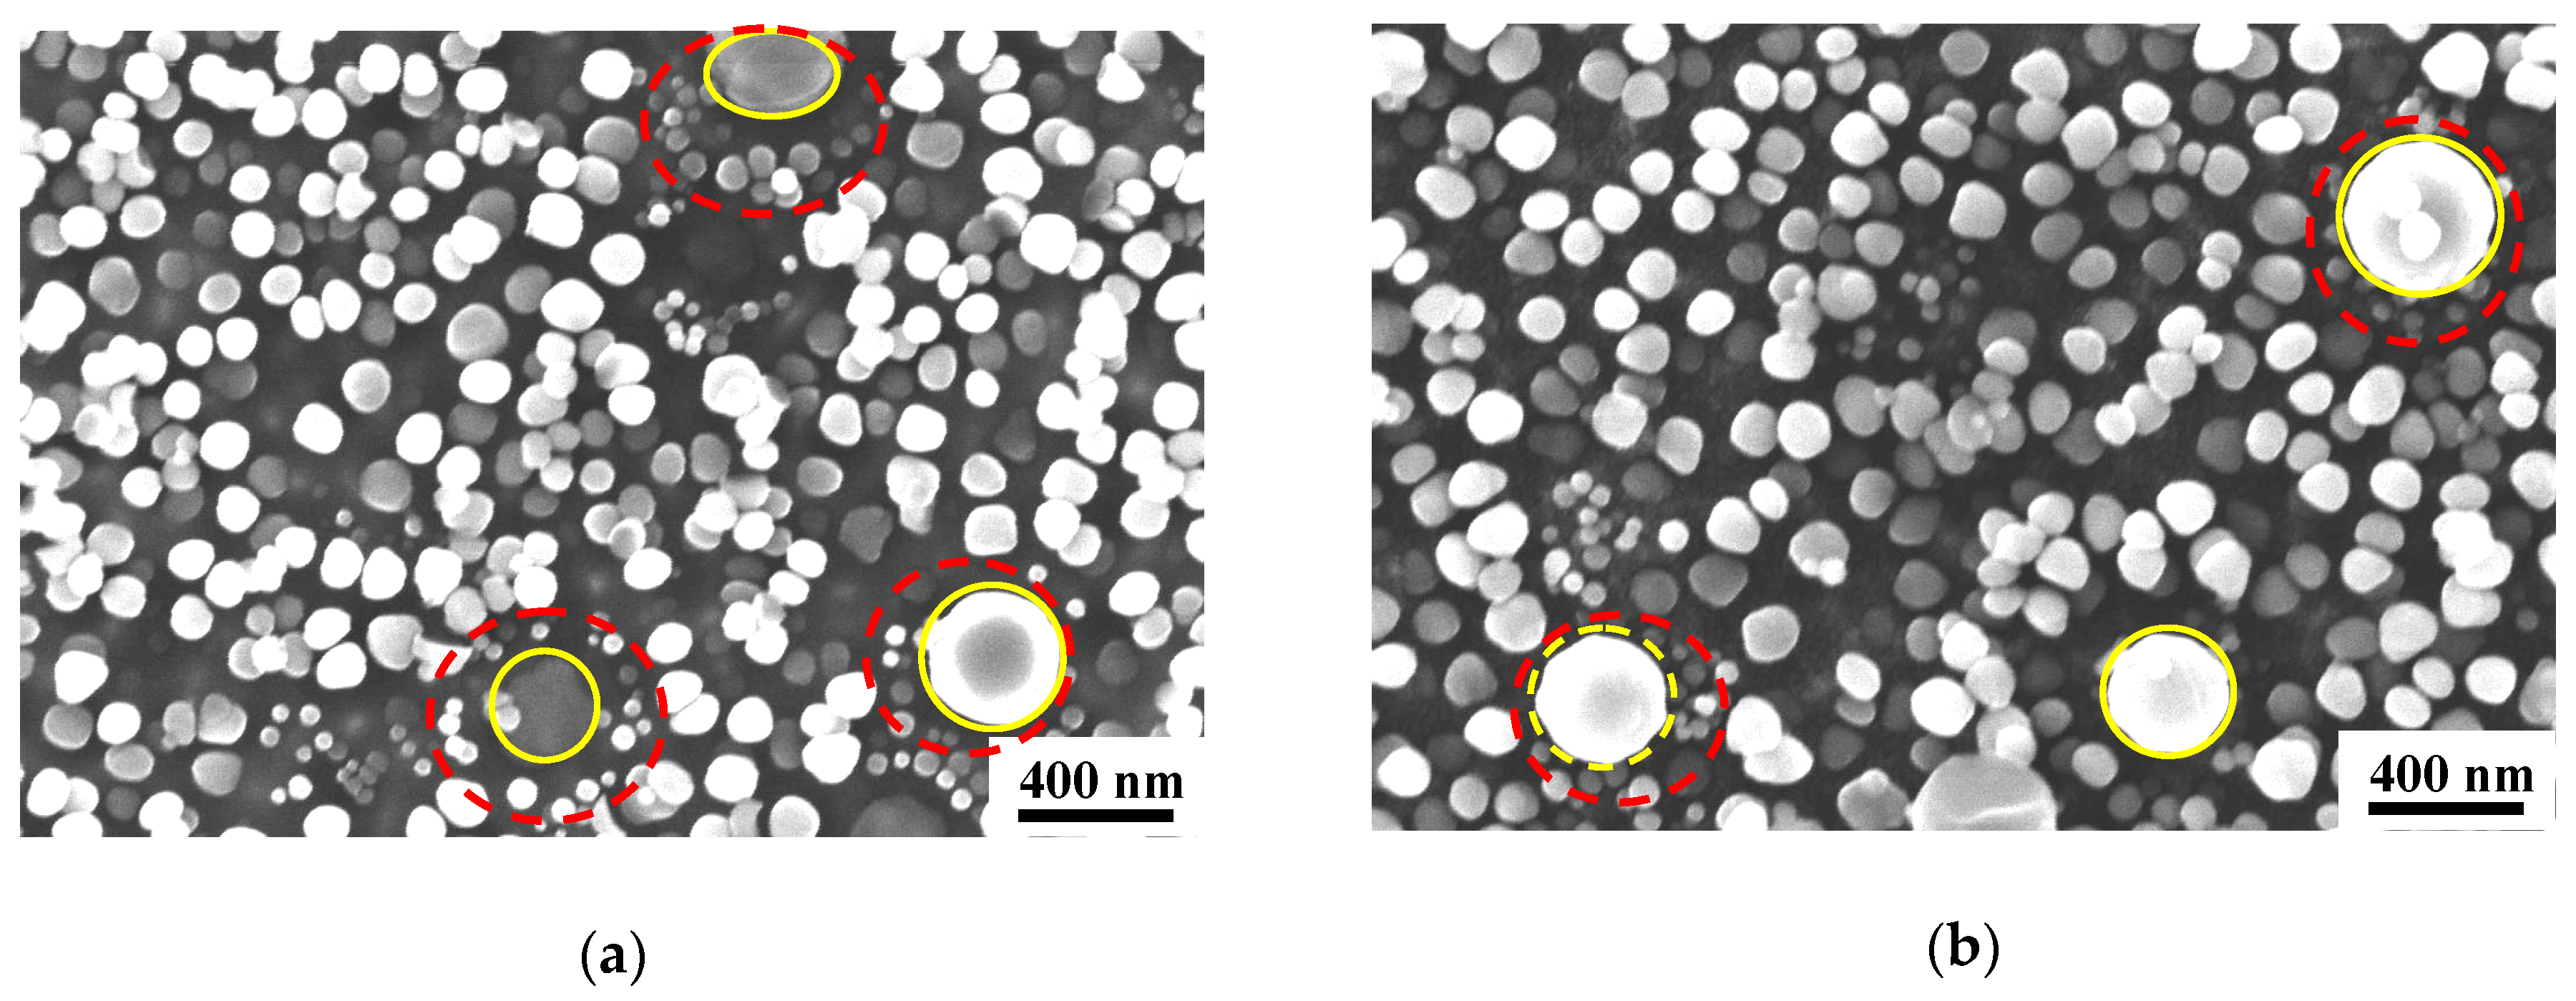

Influence and Sensitivity of Temperature and Microstructure on the Fluctuation of Creep Properties in Ni-Base Superalloy
Abstract
1. Introduction
2. Materials and Methods
3. Mechanical Properties
3.1. Creep Residual Strain
3.2. Low Cycle Fatigue
3.3. The Tensile Yield Strength
4. Microstructure Examination
4.1. Creep Sensitivity After Solution Temperature at 1040 °C
4.2. Creep Performance After Solution Temperature at 1020 °C
4.3. The Influence of Cooling Rate on Microstructure
5. Discussion
5.1. The Evolution of γ′ Phases with Solution Temperature
5.2. The Temperature Sensitivity of the Dissolution of Primary γ′I Phases
5.3. The Effect of Al + Ti Content on γ′ Phases
6. Conclusions
- (1)
- Following heat treatment with a solution temperature of 1020 °C, there was a high primary γ′I phase content, which is beneficial to maintaining a low creep residual strain. By increasing the cooling rate after solution heat treatment by adopting an oil cooling method, the number of fine precipitate phases increased significantly, which greatly improved the yield strength of the alloy. Following heat treatment with a solution temperature of 1040 °C, there were significant fluctuations in the value of creep residual strain and low cycle fatigue performance.
- (2)
- The essential reason for the dramatic fluctuation of creep performance is the distribution of γ′I phases of different sizes and quantities in the alloy, especially following solution heat treatment in the temperature sensitivity zone of the γ′I phase, which is likely to cause huge fluctuations in number of tertiary γ′III phases. In this morphology regime, the more tertiary γ′III phases, the lower the creep residual strain.
- (3)
- It is proposed that there is a temperature zone for solution heat treatment of particular sensitivity for γ′I phases, and heat treatments performed in this temperature range are likely to cause performance fluctuations. The experimental alloy investigated has this temperature sensitivity around 1040 °C.
- (4)
- The solution temperature to achieve stable properties should be adjusted according to the Al + Ti content of the alloy. An increase in the γ′ content will increase the dissolution temperature of γ′ phases. In order to keep the mechanical properties stable and avoid large fluctuations, the influence of the temperature-sensitive zone for the γ′ phase at the specific Al + Ti content should be considered.
Author Contributions
Funding
Acknowledgments
Conflicts of Interest
Data Availability
References
- Chang, K.M.; Liu, X.B. Effect of content on the mechanical behavior of the Waspaloy alloy system. Mater. Sci. Eng. A 2001, 308, 3081–3088. [Google Scholar] [CrossRef]
- Semiatin, S.L.; Fagin, P.N.; Glavicic, M.G.; Raabec, D. Deformation behavior of Waspaloy at hot-working temperatures. Scr. Mater. 2004, 50, 625–629. [Google Scholar] [CrossRef]
- Penkalla, H.J.; Wosik, J.; Czyrska-Filemonowicz, A. Quantitative microstructural characterisation of Ni-base superalloys. Mater. Chem. Phys. 2003, 81, 417–423. [Google Scholar] [CrossRef]
- Yao, Z.H.; Dong, J.C.; Zhang, M.C.; Zheng, L. Relationships between microstructures and properties for GH864 superalloy. Rare Met. Mater. Eng. 2010, 9, 1565–1570. [Google Scholar]
- Ai, C.; Zhao, X.B.; Zhou, J.; Zhang, H.; Liu, L.; Pei, Y.L.; Li, S.S.; Gong, S.K. Application of a modified Ostwald ripening theory in coarsening of γ′ phases in Ni based single crystal superalloys. J. Alloys Compd. 2015, 632, 558–562. [Google Scholar] [CrossRef]
- Wojcik, T.; Rath, M.; Kozeschnik, E. Characterisation of secondary phases in Ni-base superalloy Rene 65. J. Mater. Sci. Technol. 2018, 34, 1558–1564. [Google Scholar] [CrossRef]
- Chen, Y.Q.; Francis, E.; Robson, J.; Preuss, M.; Haigh, S.J. Compositional variations for small-scale gamma prime (γ′) precipitates formed at different cooling rates in an advanced Ni-based superalloy. Acta Mater. 2015, 85, 199–206. [Google Scholar] [CrossRef]
- Goodfellow, A.J.; Galindo-Nava, E.I.; Christofidou, K.A.; Christofidou, N.G.; Jones, T.M.; Bagot, P.A.J.; Boyer, C.D.; Hardy, M.C.; Stone, H.J. Gamma prime precipitate evolution during aging of a model Nickel-based superalloy. Metall. Mater. Trans. 2017, 49, 718–728. [Google Scholar] [CrossRef]
- Collins, D.M.; Conduit, B.D.; Stone, H.J.; Hardy, M.C.; Conduit, G.J.; Mitchell, R.J. Grain growth behaviour during near-γ′ solvus thermal exposures in a polycrystalline Nickel-base superalloy. Acta Mater. 2013, 61, 3378–3391. [Google Scholar] [CrossRef]
- Singh, A.R.P.; Nag, S.; Hwang, J.Y.; Viswanathan, G.B.; Tiley, J.; Srinivasan, R.; Fraser, H.L.; Banerjee, R. Influence of cooling rate on the development of multiple generations of γ′ precipitates in a commercial nickel base superalloy. Mater. Charact. 2011, 62, 878–886. [Google Scholar] [CrossRef]
- Collins, D.M.; Yan, L.; Marquis, E.A.; Connor, L.D.; Ciardiello, J.J.; Evans, A.D.; Stone, H.J. Lattice misfit during aging of a polycrystalline Nickel-base superalloy. Acta Mater. 2013, 61, 7791–7804. [Google Scholar] [CrossRef]
- Kelekanjeri, V.S.K.G.; Gerhardt, R.A. Etch pit and γ′ precipitate evolution in controlled Waspaloy microstructures aged at 725, 800 and 875 °C. Acta Mater. 2009, 57, 616–627. [Google Scholar] [CrossRef]
- Monajati, H.; Jahazi, M.; Bahrami, R.; Yue, S. The influence of heat treatment conditions on γ′ characteristics in Udimet® 720. Mater. Sci. Eng. A 2004, 373, 286–293. [Google Scholar] [CrossRef]
- Roebuck, B.; Cox, D.; Reed, R. The temperature dependence of γ′ volume fraction in a Ni-based single crystal superalloy from resistivity measurements. Scr. Mater. 2001, 44, 917–921. [Google Scholar] [CrossRef]
- Jian, M. Gamma Prime Precipitation Modeling and Strength Responses in Powder Metallurgy Superalloys. Ph.D. Thesis, West Virginia University, Morgantown, WV, USA, 2002. [Google Scholar]
- DʹSouza, N.; Li, W.; Argyrakis, C.; West, G.D.; Slate, C.D. On the evolution of primary gamma prime precipitates during high temperature and high strain rate deformation and subsequent heat treatment in the Ni-based superalloy, RR1000. Metall Mater. Trans. A 2019, 50, 4205–4222. [Google Scholar] [CrossRef]
- Ojo, O.A.; Tancret, F. Clarification on “Thermo-Calc and Dictra simulation of constitutional liquation of gamma prime (γ′) during welding of Ni-base superalloys”. Comput. Mater. Sci. 2009, 45, 388–389. [Google Scholar] [CrossRef]
- Singh, A.R.P.; Nag, S.; Chattopadhyay, S.; Ren, Y.; Tiley, J.; Viswanathan, G.B.; Fraser, H.L.; Banerjee, R. Mechanisms of precipitation of different generations of γ’ precipitates during continuous cooling of a nickel base superalloy (preprint). Acta Mater. 2013, 61, 280–293. [Google Scholar] [CrossRef]
- Klepser, C.A. Effect of continuous cooling rate on the precipitation of gamma prime in nickel-based superalloys. Acta Metall. Mater. 1995, 33, 589–596. [Google Scholar] [CrossRef]
- Menon, S. Microstructural characterization of Nickel-based superalloys. Microsc. Microanal. 2005, 11, 1668–1669. [Google Scholar] [CrossRef][Green Version]
- Osada, T.; Gu, Y.F.; Nagashima, N.; Yuan, Y.; Yokokawa, T.; Harada, H. Optimum microstructure combination for maximizing tensile strength in a polycrystalline superalloy with a two-phase structure. Acta Mater. 2013, 61, 1820–1829. [Google Scholar] [CrossRef]
- Ardell, A.J. Trans-interface-diffusion-controlled coarsening of γ′ precipitates in ternary Ni-Al-Cr alloys. Acta Mater. 2013, 61, 7828–7840. [Google Scholar] [CrossRef]
- Kelekanjeri, V.S.K.G.; Moss, L.K.; Gerhardt, R.A.; Ilavsky, J. Quantification of the coarsening kinetics of γ′ precipitates in Waspaloy microstructures with different prior homogenizing treatments. Acta Mater. 2009, 57, 4658–4670. [Google Scholar] [CrossRef]
- Wosik, J.; Dubiel, B.; Kruk, A. Stereological estimation of microstructural parameters of nickel-based superalloy Waspaloy using TEM methods. Mater. Charact. 2001, 46, 119–123. [Google Scholar] [CrossRef]
- Liu, T.; Yang, M.; Wang, J.; Dong, J.; Wang, L.; Lou, L. Effect of Long-term Thermal Exposure on Microstructure and Stress Rupture Properties of GH3535 Superalloy. Acta Metall. Sin. Engl. Lett. 2018, 32, 116–211. [Google Scholar] [CrossRef]
- Peng, T.; Yang, B.; Yang, G.; Wang, L.; Gong, Z. Microstructural evolution and mechanical properties of Nimonic 105 alloy aged at 750 °C. J. Alloys Compd. 2019, 789, 375–411. [Google Scholar] [CrossRef]
- Tiley, J.; Viswanathan, G.B.; Srinivasan, R.; Banerjee, R.; Dimiduk, D.M.; Fraser, H.L. Coarsening kinetics of γ′ precipitates in the commercial nickel base Superalloy René 88 DT. Acta Mater. 2009, 57, 2538–2549. [Google Scholar] [CrossRef]
- Dobeš, F.; Pešička, J.; Kratochvíl, P. Creep of Fe-18Al-4Cr alloy with zirconium addition. Intermetallics 2010, 18, 1353–1356. [Google Scholar] [CrossRef]
- Devaux, A.; Naze, L.; Molins, R.; Pineau, A.; Organista, A.; Guedou´, J.Y.; Uginet, J.F.; Heritier, P. Gamma double prime precipitation kinetic in Alloy 718. Mater. Sci. Eng. A 2008, 486, 117–122. [Google Scholar] [CrossRef]
- Zhao, S.Q.; Xie, X.S.; Smith, G.D.; Patel, S.J. Gamma prime coarsening and age-hardening behaviors in a new nickel base superalloy. Mater. Lett. 2004, 58, 1784–1787. [Google Scholar] [CrossRef]
- Picasso, A.; Somoza, A.; Tolley, A. Nucleation, growth and coarsening of γ′-precipitates in a Ni-Cr-Al-based commercial superalloy during artificial aging. J. Alloys Compd. 2009, 479, 129–133. [Google Scholar] [CrossRef]
- Morris, M.A.; Lipe, T.; Morris, D.G. Strain-aging, strain-rate sensitivity, and flow stress variations at intermediate temperatures in a two-phase Ti-Al alloy. Scr. Mater. 1996, 34, 1337–1343. [Google Scholar] [CrossRef]
- Chen, L.J. Tensile creep behavior and strain-rate sensitivity of superalloy GH4049 at elevated temperatures. Mater. Sci. Eng. A 2010, 527, 1120–1125. [Google Scholar] [CrossRef]
- Kim, W.J. Variation of true strain-rate sensitivity exponent as a function of plastic strain in the PM processed superplastic 7475Al + 0.7Zr alloy. Mater. Sci. Eng. A 2000, 277, 134–142. [Google Scholar] [CrossRef]
- Bolton, J. Reliable analysis and extrapolation of creep rupture data. Int. J. Press. Vessel. Pip. 2017, 157, 1–19. [Google Scholar] [CrossRef]
- Guo, X.; Zheng, W.; An, W.; Antonov, S.; Li, L.; Cormier, J.; Feng, Q. High temperature creep behavior of a cast polycrystalline nickel-based superalloy K465 under thermal cycling conditions. Materialia 2020, 100913. [Google Scholar] [CrossRef]
- Sarosi, P.M.; Viswanathan, G.B.; Whitis, D.; Mills, M.J. Imaging and characterization of fine γ′ precipitates in a commercial nickel-base superalloy. Ultramicroscopy 2005, 103, 83–93. [Google Scholar] [CrossRef]
- Risbet, M.; Feaugas, X.; Guillemer-Neel, C.; Clavel, M. Stereological characterization of the γ’ particles in a nickel base superalloy: Comparison between transmission electron microscopy and atomic force microscopy techniques. Mater. Charact. 2008, 59, 1252–1257. [Google Scholar] [CrossRef]
- Szczotok, A.; Richter, J.; Cwajna, L.J. Stereological characterization of γ phase precipitation in CMSX-6 monocrystalline nickel-base superalloy. Mater. Charact. 2009, 60, 1114–1119. [Google Scholar] [CrossRef]
- Tancret, F. Thermo-Calc and Dictra simulation of constitutional liquation of gamma prime (γ′) during welding of Ni base superalloys. Comput. Mater. Sci. 2007, 41, 13–19. [Google Scholar] [CrossRef]
- Yao, Z.H.; Dong, J.X.; Zhang, M.C.; Zhang, Y.F.; Xie, W.; Li, P.C. Composition optimization design and verification for nickel based high strength superalloy GH4738. Rare Met. Mater. Eng. 2017, 46, 3382–3387. [Google Scholar]
- Masoumia, F.; Jahazi, M.; Shahriari, D.; Cormier, J. Coarsening and dissolution of γ′ precipitates during solution treatment of AD730™ Ni-based superalloy: Mechanisms and kinetics models. J. Alloys Compd. 2016, 658, 981–995. [Google Scholar] [CrossRef]

| Elements | C | Cr | Mo | Ti | Al | Co | Zr | B | Al + Ti | Ni |
|---|---|---|---|---|---|---|---|---|---|---|
| Alloy1 | 0.04 | 19.36 | 4.34 | 3.03 | 1.36 | 13.55 | 0.052 | 0.0054 | 4.39 | Balance |
| Alloy2 | 0.04 | 19.39 | 4.32 | 3.04 | 1.39 | 13.52 | 0.056 | 0.0048 | 4.43 | Balance |
| Alloy3 | 0.05 | 19.37 | 4.32 | 3.10 | 1.38 | 13.69 | 0.046 | 0.0043 | 4.48 | Balance |
| Heat Treatment | Al + Ti, wt% | 1020 °C/4 h/AC + 845 °C/4 h/AC + 760 °C/16 h/AC | 1020 °C/4 h/OC + 845 °C/4 h/AC + 760 °C/16 h/AC |
|---|---|---|---|
| Alloy1 | 4.39 | 780.1 | 909.3 |
| Alloy2 | 4.43 | 769.9 | 924.6 |
| Alloy3 | 4.48 | 810.2 | 960.0 |
Publisher’s Note: MDPI stays neutral with regard to jurisdictional claims in published maps and institutional affiliations. |
© 2020 by the authors. Licensee MDPI, Basel, Switzerland. This article is an open access article distributed under the terms and conditions of the Creative Commons Attribution (CC BY) license (http://creativecommons.org/licenses/by/4.0/).
Share and Cite
Yao, Z.; Zhou, B.; Yao, K.; Wang, H.; Dong, J.; Davey, T. Influence and Sensitivity of Temperature and Microstructure on the Fluctuation of Creep Properties in Ni-Base Superalloy. Materials 2020, 13, 4758. https://doi.org/10.3390/ma13214758
Yao Z, Zhou B, Yao K, Wang H, Dong J, Davey T. Influence and Sensitivity of Temperature and Microstructure on the Fluctuation of Creep Properties in Ni-Base Superalloy. Materials. 2020; 13(21):4758. https://doi.org/10.3390/ma13214758
Chicago/Turabian StyleYao, Zhihao, Biao Zhou, Kaijun Yao, Hongying Wang, Jianxin Dong, and Theresa Davey. 2020. "Influence and Sensitivity of Temperature and Microstructure on the Fluctuation of Creep Properties in Ni-Base Superalloy" Materials 13, no. 21: 4758. https://doi.org/10.3390/ma13214758
APA StyleYao, Z., Zhou, B., Yao, K., Wang, H., Dong, J., & Davey, T. (2020). Influence and Sensitivity of Temperature and Microstructure on the Fluctuation of Creep Properties in Ni-Base Superalloy. Materials, 13(21), 4758. https://doi.org/10.3390/ma13214758

